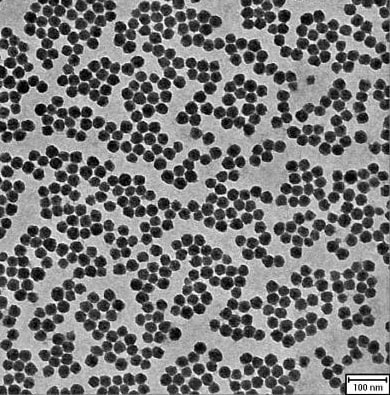

硅溶胶是3-150nm的纳米二氧化硅的水分散液,其外观和电镜照片如下:

硅溶胶外观 硅溶胶的电镜照片
硅溶胶被广泛应用于各种催化剂载体的制备,是因为硅溶胶具有很大的比表面积,例如10nm的硅溶胶其比表面积为200-300m2/g。用硅溶胶制备催化剂载体在气固催化反应中能够提供很大的催化反应面积,加速催化速度,提高生产效率,而且硅溶胶的主要成分是二氧化硅,无毒,惰性。目前,我的硅溶胶主要面向以下三个领域:(1)汽车尾气的三元催化器。(2)火电厂烟气脱硝处理装置。(3)石油化工领域。一、汽车尾气的三元催化器汽车排气管中都安装有三元催化器,用于将发动机尾气进行充分分解,减少空气污染。这类催化剂是在氧化铝制备的蜂窝状的支架上面涂敷硅溶胶和催化活性物质,因为硅溶胶有很大的比表面积,因此可以加快催化反应速度。


二、火电厂烟气脱硝处理装置




 催化剂行业对硅溶胶产品性能有极高的要求,例如比表面积准确、钠含量低、硫酸根和氯根的含量极低等。每个客户的要求都不一样,需要根据客户的要求进行定制。我多年来致力于硅溶胶产品的深度研发与生产,可以为客户定制各种性能指标的硅溶胶产品,使我们能够为合作伙伴提供更加完美的硅溶胶产品和催化剂相关问题的解决方案。
催化剂行业对硅溶胶产品性能有极高的要求,例如比表面积准确、钠含量低、硫酸根和氯根的含量极低等。每个客户的要求都不一样,需要根据客户的要求进行定制。我多年来致力于硅溶胶产品的深度研发与生产,可以为客户定制各种性能指标的硅溶胶产品,使我们能够为合作伙伴提供更加完美的硅溶胶产品和催化剂相关问题的解决方案。
Tags:我公司的硅溶胶产品在催化剂领域的应用情况
| 上一条:我公司成功开发水性木器漆专用硅溶胶 | 下一条:我公司的硅溶胶参数可以定制吗? |




